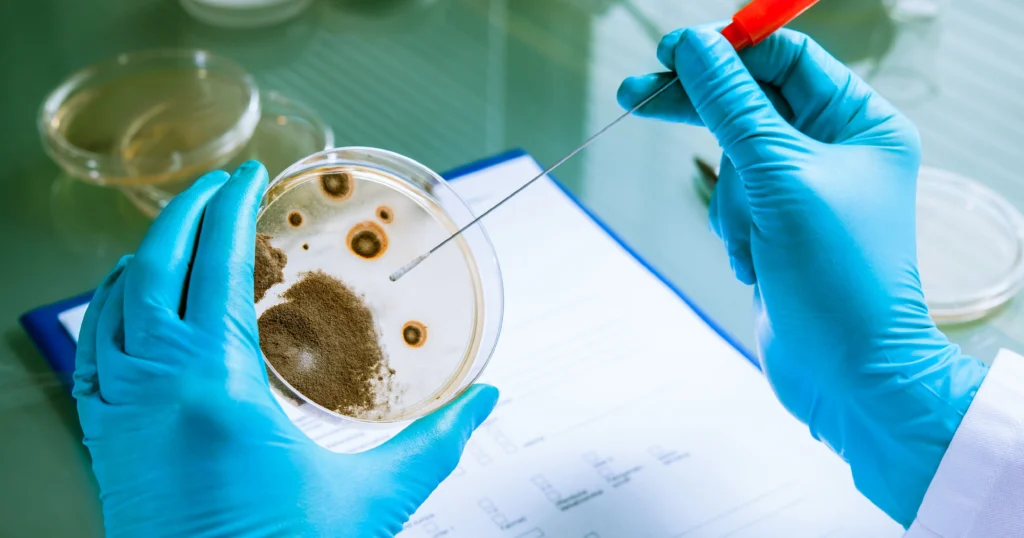

Poppers is a colloquial term for a class of chemical substances known as alkyl nitrites, which include compounds such as amyl nitrite, butyl nitrite, isobutyl nitrite, and isopropyl nitrite. These
Day: May 20, 2025
Ibogaine: A Powerful Psychedelic for Addiction Treatment and Spiritual HealingIbogaine: A Powerful Psychedelic for Addiction Treatment and Spiritual Healing
Ibogaine is a naturally occurring psychoactive compound derived from the root bark of the Tabernanthe iboga plant, native to Central and West Africa. Traditionally used in Bwiti spiritual ceremonies in
Fentanyl: Understanding Its Impact, Risks, and ManagementFentanyl: Understanding Its Impact, Risks, and Management

Fentanyl is a potent synthetic opioid that has become a central focus in discussions about the opioid crisis due to its significant role in overdose deaths. Originally developed for medical
Machiavellianism: The Psychology of Strategic Manipulation and PowerMachiavellianism: The Psychology of Strategic Manipulation and Power

Machiavellianism is a term that has transcended its historical roots to become a central concept in modern psychology, leadership theory, business ethics, and interpersonal relationships. Originally derived from Niccolò Machiavelli’s
Phospholipid: Structure, Function, and Biological SignificancePhospholipid: Structure, Function, and Biological Significance

Phospholipids are essential molecules that play a pivotal role in the structure and function of all living cells. As a major component of cell membranes, they help maintain the integrity,
Understanding Denatured Alcohol: Uses, Risks, and Safety PrecautionsUnderstanding Denatured Alcohol: Uses, Risks, and Safety Precautions

Denatured alcohol is a widely used substance in various industries, particularly in cleaning, manufacturing, and even in the production of personal care items. While many people encounter denatured alcohol regularly,
Understanding the Prefrontal Cortex: The Brain’s Decision-Making PowerhouseUnderstanding the Prefrontal Cortex: The Brain’s Decision-Making Powerhouse

The prefrontal cortex is widely recognized as one of the most critical parts of the human brain. It plays a pivotal role in many high-level functions, from decision-making to emotional
Dr. Martha Bernal: A Trailblazer in Psychology and Advocate for Diversity in Mental HealthDr. Martha Bernal: A Trailblazer in Psychology and Advocate for Diversity in Mental Health

Introduction to Dr. Martha Bernal: The First Latina with a Psychology Ph.D. in the U.S. Dr. Martha Bernal holds a pivotal place in the history of psychology, not merely for
Napoleon Dynamite: A Cult Classic That Redefined Indie CinemaNapoleon Dynamite: A Cult Classic That Redefined Indie Cinema

Napoleon Dynamite is more than just a quirky comedy—it is a cultural touchstone that left an indelible mark on early 2000s cinema. With its unique humor, unforgettable characters, and minimalist
Top 10 Most Attractive Tourist Destinations Around the World: A Guide to the Best Places to Visit in 2025Top 10 Most Attractive Tourist Destinations Around the World: A Guide to the Best Places to Visit in 2025

Traveling is one of the best ways to escape the mundane and experience new cultures, cuisines, and breathtaking landscapes. Whether you’re looking for adventure, relaxation, or cultural enrichment, the world

